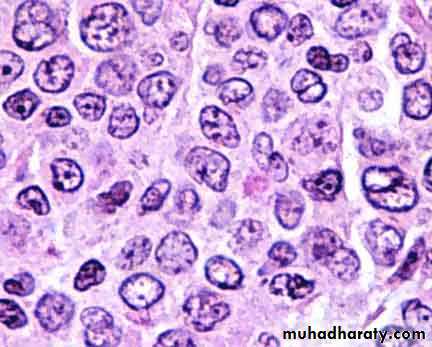
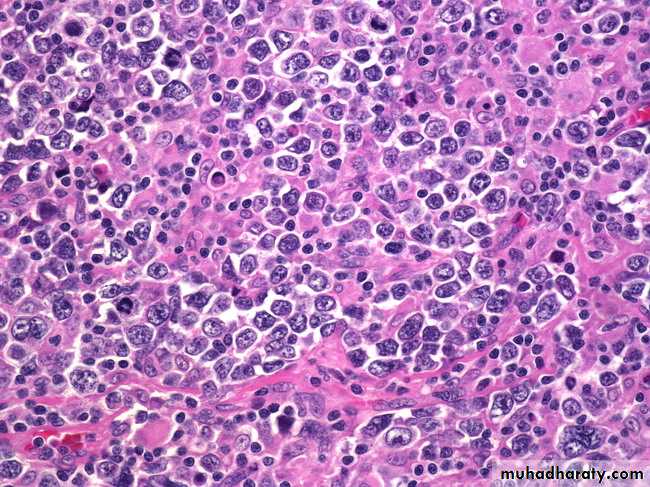

Malignant lymphomas (Non-Hodgkin's lymphomas-NHLs)
Malignancies of the lymphoid system which primarily manifest themselves outside the bone marrow, at the sites of normal lymphoid homingLymph nodes
Spleen
M.A.L.T.
Anywhere(Lymphomas outside lymph nodes and spleen are referred to as extranodal lymphomas)
Clinical presentation
Enlarging mass(es), typically painless, at sites of nodal tissueCompression, infiltration of hollow organs
Pain, obstruction, perforation
Interference with normal organ function-
Solid organ infiltration- kidneys, liver, bone marrow
Systemic symptoms
Fever
Night sweats
Weight loss
If marrow infiltrated, can have leukemic component
REAL/WHO classification- backbone
B cell neoplasmsPrecursor B cells-related to acute leukemia
Peripheral B cell lymphomas- the majority of B cell lymphomas
T cell and Natural Killer cell neoplasms
Precursor T cells
Peripheral T cell and NK neoplasms
Hodgkin’s lymphoma
Frequency of lymphomas
Example Indolent Lymphoma:Follicular lymphoma.
ClinicalMost common type of indolent lymphoma in US; second most common type lymphoma overall
Disease of adults >40 (median age 59)
Usually widely disseminated at diagnosis, incl. bone marrow
Will respond to “gentle chemotherapy” but will relapse
Overall 5 yr survival 72%
Over time, additional mutations --> progression (“transformation”) to large cell lymphoma --> aggressive clinical course
Although Gr.1 is most common presentation, some patients present with predominance of large cells within follicles -->more aggressive clinical course
Pathogenesis:
Due to t(14;18)(q32, q21)
Upregulates expression of an anti-apoptotic protein Bcl2
Follicular lymphoma
Epidemiology:• FL accounts for about 20% of all lymphomas
• Highest incidence in USA and Western Europe
• Median age 6th decade.
• rarely occurs < 20
• M/F = 1/1.7
• Paediatric cases predominantly males
Sites of involvement:
• Predominantly LN, but also BM, Spleen, Peripheral blood, GIT, soft tissue, Skin
Follicular lymphoma.
Follicular lymphoma.
Follicular lymphoma or Reactive hyperplasia
Low Power (Architectural)Benign
Malignant• Loosely packed follicles
• Polymorphic follicles
• Prominent mantle zones
• Polarized follicles
• Preserved open sinuses
• No capsular invasion or transgression
• Polyclonal light chain expression
• Non-reactive for BCL-2
• Tightly packed follicles
• Monomorphic follicles
• Absent or obscured mantle zones
• Unpolarized follicles
• Destroyed and constricted sinuses
• Extension into perinodal soft tissue
• Monoclonal light chain expression
• Reactive for BCL-2
High Power (Cytological)
BenignMalignant
• A very high mitotic rate
• Tingible-body macrophages
• Between follicles are the usual paracortical lymphoid cells
• A lower mitotic rate
• No Tingible-body macrophages
• Between follicles atypical cleaved cells may be found
Examples: aggressive B cell lymphoma-Diffuse large B cell lymphoma
ClinicalMost common lymphoma- 30% NHL
Disease of adults and children, but median age 64
Limited versus widespread disease ~1:1
Presents with rapidly enlarging masses
Approximately 40% curable with aggressive chemotherapy/ stem cell transplant
Pathogenesis
Not as clearly defined as previous examples- several cytogenetic abnormalities associated with large cell lymphoma, but no defining oneDiffuse Large B cell lymphoma
PathologyBenign equivalent- large replicating B cells of germinal center and paracortex
Diffuse infiltration of lymph node
Often necrosis; increased mitotic rate
Cytology: Oval or cleaved nucleus with vesicular chromatin and 1-3 nucleolus
Nucleus larger than that of reactive macrophage
Several cytologic subtypes initially felt to have differing clinical behavior.
Burkitt's lymphoma
Clinical3% lymphomas
Disease of adults and children- median age 31
Initially recognized in Africa by Thomas Burkitt
Association with Epstein Barr virus infection
Localization in jaw
In US, usually presents in ileocecal region of children
1/3 of all childhood lymphomas
Earlier, very aggressive and rapidly fatal
Now, ~70-80% children curable
40% of adults
Pathogenesis:
t(8;14), producing upregulation of myc oncogene, a cell cycle regulation geneBurkitt's lymphoma
PathologyBenign equivalent is replicating small noncleaved cell of germinal center:
Diffuse infiltration of lymph node
Very high mitotic rate,
Attracts macrophages to phagocytize> starry sky pattern at low power
Cytology: round nucleus, smaller than that of reactive macrophage
Vesicular chromatin and 2-5 nucleoli
Immunophenotype:
Positive: Monoclonal light chain, CD19, CD10
Negative: CD5
Mantle cell lymphoma
Clinical6% lymphomas
Disease of adults (median age 63)
Usually widely disseminated
Poor response to all attempted therapies,
? curable with transplant
5yr survival 27%
Pathogenesis
Due to t(11;14)
Upregulates Bcl1 (cyclin D1), a cell cycle regulator
Mantle Cell Lymphoma
MCL accounts for 3-10% of NHLMiddle age – older patients
Male > Female
LN +/- Spleen, BM, Peripheral blood
Extranodal sites : GIT and Waldeyer’s ring
Prognosis poor, median survival 3-4 years
Genetic hallmark: t(11;14)(q13:q32) CCND1/1GH translocation -> Cyclin D1 over-expression
CD20,CD19, CD79a, PAX5 , CD5 & Cyclin D1 positive
CD23 negative
MCL
CLL/SLL
Most common leukaemia in adults in the western world
6.7% of all NHL biopsies
Indolent Clinical course
Generalised lymhadenopathy + leukaemic phase
Diffuse growth of small lymphocytes with prolymphocytes and paraimminoblasts in Proliferation Centres
Trisomy 12 (33%), 13q (25%)
Transformation to large cell lymphoma in 5% of cases
Positive for PAX5, CD22, CD19, CD20, CD5, CD23 and CD79a
Cyclin D1 negative
CLL/SLL
Peripheral T cell lymphomasPredominantly leukemic/disseminated
T-cell prolymphocytic leukemia
T-cell large granular lymphocytic (LGL) leukemia
NK cell leukemia
Adult T-cell leukemia/lymphoma
Predominantly nodal
Angioimmunoblastic T-cell lymphoma
Peripheral T-cell lymphoma unspecified
Anaplastic large cell lymphoma, T/null-cell
Predominantly extranodal
Mycosis fungoides
Sezary syndrome
Primary cutaneous CD30+ T-cell lymphoproliferative disorders
Subcutaneous panniculitis-like T-cell lymphoma
NK/T cell lymphoma, nasal and nasal-type
Enteropathy-type intestinal T-cell lymphoma
Hepatosplenic T-cell lymphoma
Key points regarding T cell lymphomas
ClinicalRepresent 20% all lymphomas
More often extranodal than B
Can involve skin, midline facial area, liver
Very characteristic clinical presentations
Most diseases bad: high stage, and poorer response to therapy than B cell lymphomas of all grades
Pathogenesis:
Characteristic cytogenetic findings associated with several types
Anaplastic large cell lymphoma- t(2;5): ALK1 gene
Hepatosplenic T cell lymphoma- Isochromosome 7
Pathology
Cytologic features not as predictive of behavior as B cell lymphomas
Anaplastic large cell lymphoma --> better prognosis than most indolent B cell lymphomas- 77% 5 year survival
Mycosis fungoides, indolent cutaneous lymphoma, incurable, but with long clinical course
Immunophenotypic studies frequently demonstrate
Loss of normal T cell associated antigens
Antigens associated with Natural Killer cell function
Immunology absolutely necessary to recognize
Clinical presentation
Enlarging mass(es), typically painless, at sites of nodal tissue
Obstruction, ulceration of hollow organs- pain, perforation
Interference with normal organ function-
Solid organ infiltration- kidneys, liver, bone marrow
Systemic symptoms
Fever
Night sweats
Weight loss
If marrow infiltrated, can have leukemic component
Clinical staging of lymphomas
Defines extent of disease; determines therapy and prognosisBased on physical, radiologic examination, bone marrow biopsy and aspiration
Ann Arbor Staging system
B symptoms- fever, weight loss > 10% body weight, night sweats